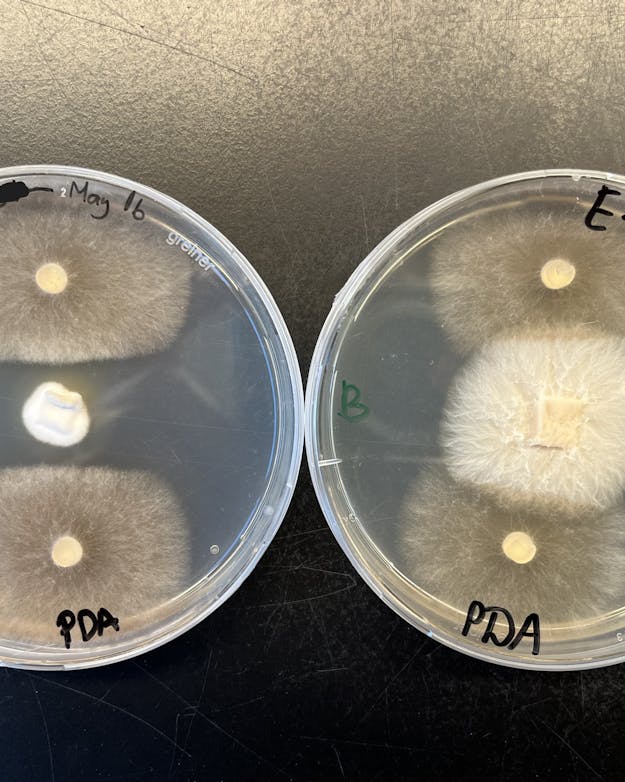

Koninklijke Barenbrug geldt als wereldwijde hofleverancier van stadiongras. Vanaf 2006 is bijna elk groot toernooi op Barenbrug-gras gespeeld, zo ook dit EK. Jaren van onderzoek gingen eraan vooraf.
Het EK voetbal nadert zijn einde. Na de finale zijn er 51 wedstrijden gespeeld op de grasmatten in Duitse voetbalstadions. Dat stadiongras moet specifieke eigenschappen hebben. Er komt minder zonlicht en wind bij, en 22 spelers rennen 90 minuten lang op noppen over de grassprieten. Ook wordt het vaak en kort gemaaid. “Daar lijdt het gras natuurlijk onder”, stelt onderzoeker Juan Castillo. Hij werkt bij Koninklijke Barenbrug, dat geldt als wereldwijde hofleverancier van stadiongras. “Elke keer dat het wordt gemaaid, is het alsof het gras een kleine beuk tegen het hoofd krijgt. Bovendien wordt met maaien in het gras gesneden, wat kan leiden tot infecties. Dat is een beetje vergelijkbaar met wanneer wij een wond op een arm hebben”, vertelt Castillo, die voor zijn tijd bij Barenbrug als plantpatholoog aan de Wageningen University & Research plantenziektes bestudeerde.
Van koeien naar voetballers
Barenbrug, dat al 120 jaar bestaat, begon met het ontwikkelen van grassen waarop koeien konden grazen. Nog steeds is dit een belangrijk onderdeel van het verdienmodel. Dit zogeheten raaigras bleek ook geschikt voor stadions. Een interessante markt, waar Barenbrug de afgelopen decennia de meest dominante speler werd. Bij het huidig EK ligt Barenbrug-gras sowieso in de speelsteden Dortmund, Leipzig en Keulen, maar waarschijnlijk in veel meer stadions (omdat het gras in de andere stadions wordt verkocht via een ondoorzichtiger verkoop- en leveranciersnetwerk, is moeilijker te volgen waar het precies vandaan komt). De afgelopen jaren was Barenbrug-gras bij elk WK en EK aanwezig, op Qatar na. Zo ongeveer de hele eredivisie speelt erop, net als de meeste grote Europese topclubs, zoals Manchester City, Real Madrid en Bayern München.

In Bernabéu, het station van Real Madrid, ligt Barenbrug-gras.
Little Savage, CC BY-SA 3.0 via Wikimedia CommonsHet is een flinke stap van wereldsteden als Manchester, Madrid en München naar Wolfheze, een bosrijk dorp van nog geen tweeduizend inwoners. Hier vind je geen topclub, maar één amateurvereniging, die zich wegens te weinig spelers dit seizoen terugtrok uit de Zaterdag Vierde Klasse (nul punten uit elf wedstrijden). Toch is er wél een link: direct naast de velden van voetbalclub Wodanseck ligt het graslaboratorium van Barenbrug.
Testen, testen en nog eens testen
In Wolfheze staat voor een fortuin aan apparatuur, waarmee onderzoekers het optimale stadiongras proberen te ontwikkelen. Je vindt er klimaatkamers, waar gras onder verschillende omstandigheden is te testen, en een machine die noppen van een voetbalschoen nabootst. In petrischaaltjes worden schimmels ontwikkeld die grassen zowel aanvallen als beschermen. En er liggen vele hectaren aan testvelden. Barenbrug (jaaromzet bijna 400 miljoen euro) heeft over de hele wereld nog 21 van dit soort research & development-plekken en werkt samen met tientallen universiteiten.
De medewerkers van Barenbrug houden zich dagelijks bezig met onderzoek naar gras. Platgeslagen komt dat onderzoek neer op zaden ontwikkelen en die daarna testen, testen en nog eens testen. Redelijk aan het begin van het onderzoek worden de beste grassen bij elkaar gezet. Door middel van bestuiving (kruising) krijgen deze grassen nakomelingen. Deze nakomelingen worden ook weer getest op verschillende omstandigheden, zoals hoe gras reageert op ziektes, noppen van een voetbalschoen, kort maaien, droogte, kou, natheid en schaduw. Ook kijken de onderzoekers bij welke temperatuur zaadjes kiemen. De resultaten noteren ze in datasystemen. Daarnaast maken drones beelden van de verschillende grasstroken op de testvelden, waarna kunstmatige intelligentie deze analyseert.
Uiteindelijk worden duizenden van deze nakomelingen getest, waarvan er geen, één of enkele grassen overblijven die geschikt zijn voor de markt. Achter de ontwikkeling van iets ogenschijnlijks simpels als een grasspriet gaan jaarlijks vele miljoenen euro’s aan onderzoek schuil, weet Castillo. Het ontwikkelen en testen gebeurt zó uitgebreid dat er ongeveer zestien jaar zit tussen het begin van het proces en het moment dat gras de commerciële markt op gaat.
Extreem droog
Omdat
het zo’n zestien jaar duurt om zaden te ontwikkelen, is een vooruitziende blik
vereist. De onderzoekers van Barenbrug houden daarom zowel klimaatwetenschap
als regelgeving in de gaten. Door klimaatverandering moet het gras onder meer
bestand zijn tegen extremer weer, zoals ernstige droogte. Daarom staat op het
terrein een halfopen, door een soort tentzeil overdekte testruimte, waarin het
extreem droog is – alsof je in de zomer in de Zuid-Spaanse streek Andalusië
bent en niet in een druilerig Wolfheze. “We hebben nu een natte zomer, maar de
verwachting is dat we vooral heel droge zomers gaan krijgen. Daarom ontwikkelen
we een zaadje waar een laag omheen zit die als een spons water opneemt”,
vertelt Castillo.
Ook de Europese Green Deal speelt een belangrijke rol bij de ontwikkeling van de graszaden. “De Green Deal zorgt ervoor dat er minder pesticiden gebruikt mogen worden in de bestrijding van ziektes. Dat geldt ook voor stadiongras en gras voor golfbanen.” Daarom richt een groot deel van het onderzoek zich nu op het ontwikkelen van innovaties die de klassieke bestrijdingsmiddelen moeten vervangen. Deels gebeurt dat via klassiek laboratoriumwerk, waarbij met petrischaaltjes en microscopen grassen en schimmels worden geanalyseerd.
De vingers van Castillo gaan over zijn iPad. Hij laat op foto’s zien hoe schimmels in staat zijn om gras in een petrischaaltje ziek te maken. Op een andere foto is duidelijk te zien hoe een schimmel het gras kan beschermen tegen een andere ziekmakende schimmel. Dat doet de ‘goede’ schimmel door een soort ondoordringbare cirkel te vormen, waar de ‘slechte’ schimmel niet doorheen kan breken, zo valt op de foto te zien. Met een speciale techniek kan deze goede schimmel in het zaad van de grasplant worden gebracht. En zo zijn er nog honderden onderzoeken en technieken die Barenbrug toepast.
Links in het midden stopt de nuttige schimmel (wit) de groei van de schimmel die grasziekte veroorzaakt (bruin). Rechts zit in het midden een witte schimmel die niet beschermt tegen de slechte variant (bruin).
Koninklijke BarenbrugCastillo deelt zijn kantoorruimte met medeonderzoeker Maarten Kuijl, die met regelmaat op de testvelden is te vinden voor onderzoek. “Het idee is dat, door al onze kennis en technieken te combineren, gras een optimale weerstand opbouwt tegen ziektes, weers- en klimaatomstandigheden, maaien en noppen”, vat hij samen. Soms beoordeelt bioloog Kuijl op een dag 1500 verschillende grassamples, wat onvermijdelijk leidt tot beroepsdeformatie. “Ik volg het EK wel, maar als ik naar het voetbal kijk, let ik vaak meer op het gras dan op de spelers.”
Dertig vrachtwagens
Van verschillende rassen maakt Barenbrug, vaak in samenspraak met een zogeheten zodenteler die de matten uiteindelijk teelt, een zadenmengsel. “Meestal verkopen we voor één mat zo’n vier tot zes verschillende rassen”, vertelt Jan van den Boom, die bij Barenbrug verantwoordelijk is voor de verkoop van onder meer stadiongras. “Op basis van de wensen van het stadion of de voetbalclub en de klimatologische omstandigheden bepalen we het ideale percentage dat van de verschillende zaadjes in het zadenmengsel terug moet komen.”
Het proces van zaaien en oogsten, dat de zodenteler uitvoert, neemt ongeveer een jaar in beslag. Het Nederlandse Hendriks Graszoden is hierbij voor Barenbrug de belangrijkste partner. Het bedrijf legt door heel Europa matten neer, aldus Van den Boom. “De matten worden in grote vrachtwagens naar de stadions gebracht. Soms zijn er wel meer dan dertig vrachtwagens nodig. Als de mat stevig genoeg wordt geoogst, kan er gelijk op gevoetbald worden – maar daar ging dus wel een ontwikkelproces van maar liefst zeventien jaar aan vooraf.”